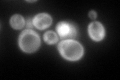
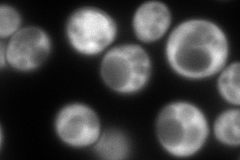
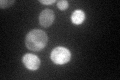

View description
Translation initiation factor eIF1A, essential protein that forms a complex with Sui1p (eIF1) and the 40S ribosomal subunit and scans for the start codon; C-terminus associates with Fun12p (eIF5B); N terminus interacts with eIF2 and eIF3
Localization:
Intensity:
Fold change:
Significance:
-
C’ GFP library in SD
cytosol207.19 -
N' NOP1pr-GFP in SD
cytosol385.506 -
N' TEF2pr-mCherry in SD

cytosol558.82 -
N' NATIVEpr-GFP in SD

missing0 -
N' TEF2pr-VC and Cyto-VN in SD

cytosol76.8306 -
C’ GFP library in SD+DTT

cytosol162.410.78No -
C’ GFP library in SD+H2O2

cytosol177.050.85No -
C’ GFP library in Starvation Media
cytosol74.560.35Yes -
C’ GFP library on the background of Pup2-DaMP

cytosol -
C’ GFP library on the background of CCT mutant

cytosol182.5170.880862No
